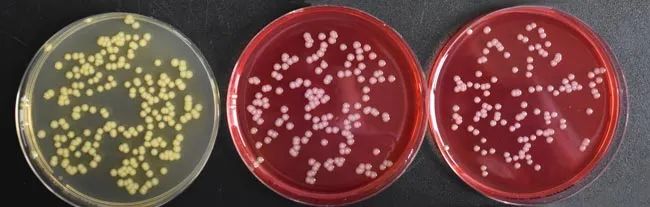
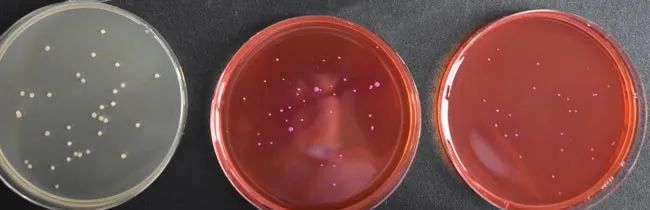

2025版《中国药典》新增通则1109 洋葱伯克霍尔德菌群检查法,该方法针对药品及生产环境中洋葱伯克霍尔德菌群(BCC)的检测建立了标准化流程。作为一类具有高度耐药性及致病性的条件致病菌,BCC污染控制对药品质量体系至关重要,而培养基的合规性与特异性则是确保检测灵敏度与准确性的核心要素。
针对国内外药典要求,青岛海博生物通过精准配方设计与严苛质控体系,为 BCC检测提供「双药典解决方案」。
01中国药典(ChP)
严格遵循2025版药典1109法配方要求,采用胰蛋白胨 - 酵母提取物复合氮源体系,辅以丙酮酸钠代谢促进因子,可显著提升 BCC 菌株的增殖效率。通过结晶紫(革兰氏阳性菌抑制剂)与庆大霉素 - 万古霉素 - 多粘菌素 B 复合抑菌体系的协同作用,实现对非目标菌的广谱抑制。
酚红为pH指示剂,按照酚红的变色指示范围:在 pH6.4~8.2时由黄变红,该培养基初始pH为 6.2±0.2,培养基颜色为黄色(如图1所示);接种后微生物生长代谢产生碱性产物时,使培养基的pH值升高,颜色变为红色,培养基接种前后颜色变化明显易于观察。
采用无菌灌装工艺预制的即用型平板,通过严格的无菌性验证(需氧菌、厌氧菌及真菌检测均为阴性)及性能适用性测试,免去自行配制的繁琐操作,可直接用于样品接种,减少实验室配制过程中的污染风险。
洋葱伯克霍尔德菌群在BCCSA上利用其碳源和氮源等营养成分生长代谢得到碱性产物,使用得培养基pH升高,颜色由初始的黄色向橘红色/玫红色转变。因此,洋葱伯克霍尔德菌群在BCCSA上培养后,形成的菌落为圆形,灰白、灰粉色或(土)黄色,菌落周围的培养基为橘红色或玫红色。
产品列表

02美国药典(USP)
完全符合USP微生物检测标准,采用乳糖 - 蔗糖双碳源设计,配合酚红酸碱指示系统,可通过菌落颜色变化识别目标菌株。结晶紫与特定浓度抗生素组合形成选择性屏障,对假单胞菌属等有抑制作用。
专为USP检测流程优化的预制平板,直径9cm适配标准涂布法与划线法操作,经ATCC菌株验证,回收率符合质控标准,适用于进出口药品的跨境检测结果互认场景。
洋葱伯克霍尔德菌 ATCC25416
洋葱伯克霍尔德菌 ATCC BAA-245
多噬伯克霍尔德氏菌 ATCC BAA-247
产品列表

2025 药典过渡在即,合规检测不能等!
联系我们,获取专属检测方案!
上一篇:海博生物HBPP瓶装液体培养基——多种包装+中和剂定制,100%匹配您的实验需求!
下一篇:青岛海博生物祝您国庆-中秋双节快乐!


 海博微信公众号
海博微信公众号
 海博天猫旗舰店
海博天猫旗舰店


 海博微信公众号
海博微信公众号
 海博天猫旗舰店
海博天猫旗舰店